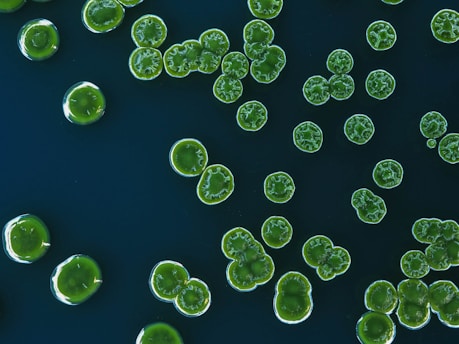

Your Gut Feeling: How Your Microbiome Impacts Type 2 Diabetes (And What You Can Do About It)
Discover how your gut microbiome impacts Type 2 diabetes! Learn actionable steps to improve gut health, boost insulin sensitivity, and stabilize blood sugar naturally. Unlock personalized strategies for better metabolic control.
7/6/20254 min read

Your Gut Feeling: How Your Microbiome Impacts Type 2 Diabetes (And What You Can Do About It)
We’re going to dive deep into something crucial for your Type 2 Diabetes management – your gut microbiome. It might sound complex, but trust me, understanding this can be a game-changer.
Think of your gut as a bustling city. Trillions of tiny residents, mostly bacteria (but also fungi, viruses, and other microorganisms), live there, forming a complex ecosystem called the gut microbiome. For a long time, we focused on what we ate. Now, science is increasingly showing that who is living in our gut plays a massive role in our overall health, especially when it comes to Type 2 Diabetes.
Why Should You Care About Your Gut Microbiome?
If you’re managing Type 2 Diabetes, you’re likely focused on blood sugar levels, insulin sensitivity, and overall metabolic health. Guess what? Your gut microbiome is deeply intertwined with all of these. Here’s how:
Improved Insulin Sensitivity: Certain types of gut bacteria help your body use insulin more effectively. A diverse and healthy microbiome can enhance insulin sensitivity, meaning your body needs less insulin to keep blood sugar levels in check.
Better Blood Sugar Control: Some gut bacteria produce short-chain fatty acids (SCFAs) like butyrate, which have been shown to improve glucose metabolism and reduce inflammation. A balanced gut can lead to more stable blood sugar levels throughout the day.
Reduced Inflammation: Chronic low-grade inflammation is a hallmark of Type 2 Diabetes and contributes to insulin resistance and complications. An imbalanced gut microbiome (dysbiosis) can promote inflammation. Nurturing a healthy gut can help dampen this inflammatory response.
Weight Management: The gut microbiome can influence how we extract energy from food and store fat. Certain bacterial compositions are linked to a higher risk of obesity, a major risk factor for Type 2 Diabetes. A healthier gut can support weight management efforts.
Gut Barrier Integrity: The lining of your gut acts as a barrier, preventing harmful substances from entering your bloodstream. An unhealthy microbiome can compromise this barrier (leaky gut), leading to increased inflammation and metabolic issues.
So, What Can You Actually Do About Your Gut Microbiome? (The Actionable Steps)
Let’s get down to the brass tacks. Here’s what you can do to cultivate a healthier gut microbiome:
1. Embrace the Power of Fiber (Especially Diverse Fiber):
Think of fiber as food for your good gut bacteria. They ferment it, producing those beneficial SCFAs. But not all fiber is created equal. Aim for a variety of high-fiber foods, including:
Fruits: Berries, apples, bananas, oranges (in moderation).
Vegetables: Leafy greens, broccoli, carrots, bell peppers, sweet potatoes.
Whole Grains: Oats, quinoa, brown rice (in moderation).
Legumes: Lentils, chickpeas, beans.
Actionable Tip: Start small if you’re not used to a high-fiber diet to avoid digestive discomfort. Gradually increase your intake. Aim for at least 25-30 grams of fiber per day.
2. Befriend Fermented Foods:
Fermented foods are packed with live beneficial bacteria (probiotics) that can directly contribute to a healthier gut microbiome. Include:
Yogurt (with live and active cultures): Opt for unsweetened varieties.
Kefir: A fermented milk drink.
Sauerkraut (unpasteurized): Fermented cabbage.
Kimchi: Spicy Korean fermented vegetables.
Tempeh: Fermented soybeans.
Actionable Tip: Introduce small amounts of fermented foods into your diet and see how your body responds.
3. Consider Prebiotic-Rich Foods:
Prebiotics are types of fiber that act as food for your existing good gut bacteria, helping them to thrive. Good sources include:
Onions and Garlic:
Asparagus:
Leeks:
Bananas (especially slightly green ones):
Oats:
Actionable Tip: Incorporate these prebiotic-rich foods regularly into your meals.
4. Limit Processed Foods, Sugary Drinks, and Artificial Sweeteners:
These can negatively impact your gut microbiome by feeding less beneficial bacteria and potentially contributing to inflammation.
Processed Foods: Often high in unhealthy fats, sugar, and artificial ingredients.
Sugary Drinks: Provide empty calories and can disrupt the gut balance.
Artificial Sweeteners: Some studies suggest they can negatively alter the gut microbiome.
Actionable Tip: Make a conscious effort to reduce your intake of these items. Focus on whole, unprocessed foods.
5. Stay Hydrated:
Water is essential for overall health, including the proper functioning of your digestive system and the health of your gut lining.
Actionable Tip: Drink plenty of water throughout the day.
6. Manage Stress:
Chronic stress can negatively impact your gut health. Practice stress-reducing techniques like:
Regular Exercise:
Spending Time in Nature:
Adequate Sleep:
Actionable Tip: Find a stress-management technique that works for you and make it a regular part of your routine.
7. Be Mindful of Medications (Especially Antibiotics):
Antibiotics are sometimes necessary but can also disrupt the balance of your gut microbiome by killing both good and bad bacteria. If you need to take antibiotics, talk to your doctor about strategies to support your gut health afterward, such as consuming probiotics.
Actionable Tip: Only take antibiotics when necessary and prescribed by a doctor. Discuss gut health support with your healthcare provider.
8. Consider Probiotic Supplements (With Caution and Guidance):
While probiotic supplements can be helpful for some, the research is still evolving, and not all probiotics are created equal. It’s best to talk to your doctor or a registered dietitian before starting any supplement, as they can help you choose a strain and dosage that might be beneficial for your specific needs.
Actionable Tip: Don't start taking probiotic supplements without professional advice. Focus on getting probiotics through whole foods first.
The Takeaway (Just Like Neil's Clear Conclusions)
Your gut microbiome is a powerful player in managing Type 2 Diabetes. By understanding its role and taking proactive steps to nurture a healthy gut, you can potentially improve your insulin sensitivity, blood sugar control, reduce inflammation, and support your overall metabolic health.
It’s not about a quick fix, but about making sustainable lifestyle changes. Just like building a successful blog takes time and consistent effort, so does cultivating a thriving gut microbiome. Start with small, manageable changes, be patient, and listen to your body. Your gut feeling might just be telling you something important about your diabetes management journey.
Now it’s your turn! What are your favorite gut-friendly foods? Have you noticed any connection between your diet and your blood sugar levels? Share your experiences and tips in the comments below – let’s learn from each other!
